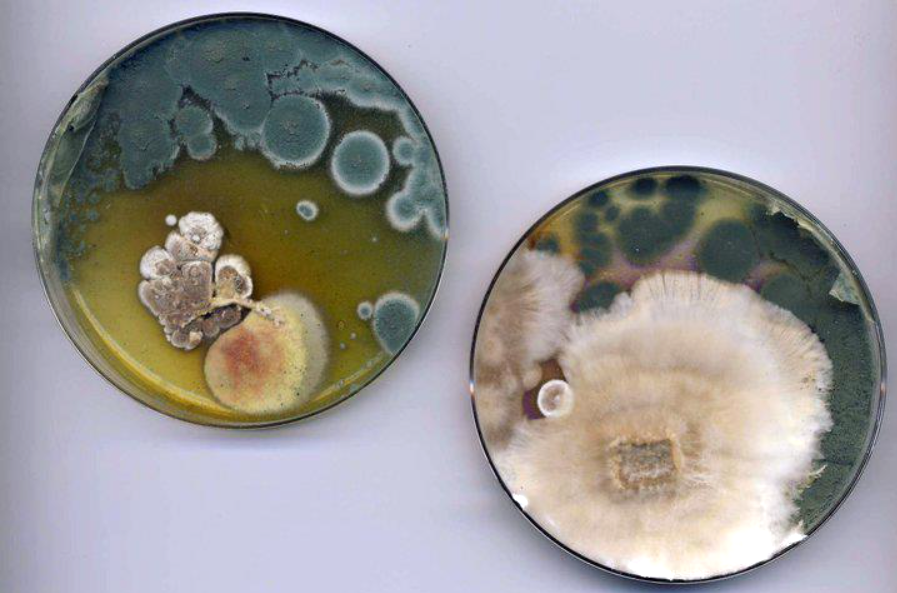
lab

Ghost Fungus mycelium colonising an agar cast of my face.

2022 Experiments with long exposures of wild Panellus stipticus

2018 Mushroom biosonification with Tosca Teran at Co:Lab during the Chaos Fungorum.
Tosca is biosonifying me here.
 
2018 Omphalotus nidiformus (glow in the dark Ghost fungus) and the green contamination is trichaderma, the most common mold that will grow on bread and things. The mycelium is producing light in my studio at the Sitka Center for Art and Ecology.

2014 Bioluminescing Armillaria (Honey Fungus) on agar

2014 Succesful liquid cultures from local wild fungi in my studio lab at Concordia University
2011 Failed attempts to isolate cultures of local wild bioluminescent fungi
|
|
FUNGAL FACES
TALKING IN THE DARK
This is what’s currently growing in my studio. These agar faces host mycelium of bioluminescent mushrooms which are hooked up to a biosensor that detects the fungi’s electrical activity and translates live data into different kinds of outputs. In theory they could be used to control the temperature and humidity in the lab.
The project offers lab fungi dominion over their environment and hopes to find a variable or context where the fungi will recognise their ability to take control of the system. It is the first iteration in an upcoming body of study where I invite scientists to suggest what actions fungi might be able to take to engage with theirlife suport system and what variables they might want to control.
The project hopes to recognise a fungal expression– chemical, metabolic, growth patterns etc. that could be trained to
ommunicate a desire for autonomy or collaboration. The work holds space for speculation between artists, scientists and
nonhuman organisms with a theme of collaborating to develop a strategy to stabilize the climate.
|